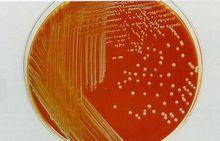
葡萄球菌α溶血
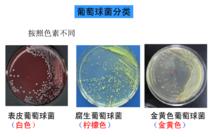
表皮葡萄球菌

形態染色
 表皮葡萄球菌
表皮葡萄球菌球形或稍呈橢園形,直徑1.0um左右,排列成葡萄狀。葡萄球菌無鞭毛,不能運動。無芽胞,除少數菌株外一般不形成莢膜。易被常用的鹼性染料著色,革蘭氏染色為陽性。其衰老、死亡或被白細胞吞噬後,以及耐藥的某些菌株可被染成革蘭氏陰性。
培養特性
營養要求不高,在普通培養基上生長良好,在含有血液和葡萄糖的培養基中生長更佳,需氧或兼性厭氧,少數專性厭氧。28-38℃均能生長,致病菌最適溫度為37℃,PH為4.5-9.8,最適為7.4。在肉湯培養基中24小時後呈均勻混濁生長,在瓊脂平板上形成圓形凸起,邊緣整齊,表面光滑,濕潤,不透明的菌落。不同種的菌標產生不同的色素,如金黃色、白色、檸檬色。色素為脂溶性。葡萄球菌在血瓊脂平板上形成的菌落較大,有的菌株菌落周圍形成明顯的全透明溶血環(β溶血),也有不發生溶血者。凡溶血性菌株大多具有致病性。
生化反應
多數葡萄球菌能分解葡萄糖、麥芽糖和蔗糖,產酸不產生氣。致病性菌株能分解甘露醇。
分類與分型
根據生化反應和產生色素不同,可分為金黃色葡萄球菌(Staph. aureus)、表皮葡萄球菌(Staph. epidermidis)和腐生葡萄球菌(Staph. saparophytics)三種:其中金黃色葡萄球菌多為致病菌,表皮葡萄球菌偶爾致病,腐生葡萄球菌一般不致病。60%-70%的金黃色葡萄球菌可被相應噬菌體裂解,表皮葡萄球菌不敏感。用噬菌體可將金葡萄菌分為4群23個型。腸毒素型食物中毒由Ⅲ和Ⅳ群金葡萄菌引起,Ⅱ群菌對抗生素產生耐藥性的速度比Ⅰ和Ⅳ群緩慢很多。造成醫院感染嚴重流行的是Ⅰ群中的52、52A、80和81型菌株。引起皰疹性和剝脫性皮炎的菌株經常是Ⅱ群71型。
抗原結構
 葡萄球菌A蛋白
葡萄球菌A蛋白葡萄球菌抗原構造複雜,已發現的在30種以上,其化學組成及生物學活性了解的僅少數幾種。1.葡萄球菌A蛋白(Staphylococcal protein A,SPA)存在於菌細胞壁的一種表面蛋白,位於菌體表面,與胞壁的粘肽相結合。它與人及多種哺乳動物血清中的lgG的 Fc 段結合,因而可用含SPA的葡萄球菌作為載體,結合特異性抗體,進行協同凝集試驗。A蛋白有抗吞噬作用,還有激活補體替代途等活性。SPA是一種單鏈多肽,與細胞壁肽聚糖呈共價結合,是完全抗原,具屬特異性。
2.多糖抗原 具有群特異性,存在於細胞壁,藉此可以分群,A群多糖抗原體化學組成為磷壁酸中的N-乙醯葡胺核糖醇殘基。B群化學組成是磷壁酸中的N-乙醯區糖胺甘油殘基。
3.莢膜抗原 幾乎所有金黃色葡萄球菌菌株的表面有莢膜多糖抗原的存在。表皮葡萄球菌僅個別是菌株有此抗原。
相關特性
(一)致病物質
金葡菌產生多種毒素與酶
血漿凝固酶
 血漿凝血酶試驗
血漿凝血酶試驗(Coagulase) 是能使含有枸椽酸鈉或肝素抗凝劑的人或兔血漿發生凝固的酶類物質,致病菌株多能產生,常作為鑑別葡萄球菌有無致病性的重要標誌。凝固酶有兩種:一種是分泌至菌體外的,稱為游離凝固酶(Free coagulase)為蛋白質。作用類似凝血酶原物質,可被人或兔血漿中的協同因子(Cofactor)激活變成凝血酶樣物質後,使液態的纖維蛋白原變成固態的纖維蛋白,從而使血漿凝固。另一種凝固酶結合於菌體表面並不釋放,稱為結合凝固酶(Bound coagulase)或凝聚因子(Chumping factor),在該菌株的表面起纖維蛋白原的特異受體作用,細菌混懸於人或兔血漿中時,纖維蛋白原與菌體受體交聯而使細菌凝聚。游離凝固酶採用試管法檢測,結合凝固酶則以玻片法測試。凝固酶耐熱,粗製品100℃30分鐘或高壓滅菌後仍保持部分活性,但易被蛋白分解酶破壞。
凝固酶和葡萄球菌的毒力關係密切。凝固酶陽性菌株進入機體後,使血液或血漿中的纖維蛋白沉積於菌體表面,阻礙體內吞噬細胞的吞噬,即使被吞噬後,也不易被殺死。同時,凝固酶集聚在菌體四周,亦能保護病菌不受血清中殺菌物質的作用。葡萄球菌引起的感染易於局限化和形成血栓,與凝固酶的生成有關。
凝固酶具有免疫原性,刺激機體產生的抗體對凝固酶陽性的細菌感染有一定的保護作用。慢性感染患者血清可有凝固酶抗體的存在。
葡萄球菌溶血素(Staphyolysin)
葡萄球菌α溶血
葡萄球菌α溶血多數致病性葡萄球菌產生溶血等。按抗原性不同,至少有α、β、γ、δ、ε五種,對人類在致病作用的主要是α溶血素。它是一種“攻擊因子”,化學成分為蛋白質,分子量約為30,000,不耐熱,65℃30分鐘即可破壞。如將α-溶血素注入動物皮內,能引起皮膚壞死,如靜脈注射,則導致動物迅速死亡。α溶血素還能使小血管收縮,導致局部缺血和壞死,並能引起平滑肌痙攣。α溶血素是一種外毒素,具有良好的抗原性。經甲醛處理可製成類毒素。
殺白細胞素(Leukocidin)
含F和S兩種蛋白質,能殺死人和兔的多形核粒細胞和巨噬細胞。此毒素有抗原性,不耐熱,產生的抗體能阻止葡萄球菌感染的復發。
腸毒素(Enterotoxin)
從臨床分離的金黃色葡萄球菌,約1/3產生腸毒素,按抗原性和等電點等不同,葡萄球菌腸毒素分A、B、C1、C2、C3、D、E和F八個血清型,細菌能產生一型或兩型以上的腸毒素,腸毒素是單一的多肽鏈,含有較多的賴氨酸、酷氨酸、天門冬氨酸和谷氨酸。腸毒素可引起急性胃腸炎即食物中毒。與產毒菌株污染了牛奶、肉類、魚是蝦、蛋類等食品有關,在20℃以上經8~10小時即可產生大量的腸毒素。腸毒素是一種可溶性蛋白質,耐熱,經100℃煮沸30分鐘不被破壞,也不受胰蛋白酶的影響,故誤食污染腸毒素的食物後,在腸道作用於內脂神經受體,傳入中樞,刺激嘔吐中樞,引起嘔吐,並產生急性胃腸炎症狀。發病急,病程短,恢復快。一般潛伏期為1~6小時,出現頭暈、嘔吐、腹瀉,發病1~2日可自行恢復,預後良好。
表皮溶解毒素(Epidermolytic toxin)
也稱表皮剝脫毒素(Exfoliatin)引起人類或新生小鼠的表皮剝脫性病變。主要發生於新生兒和嬰幼兒,引導起燙傷樣皮膚綜合徵。主要由噬菌體Ⅱ型金葡萄產生的一種蛋白質,分子量24,000,具有抗原性,可被甲醛脫毒成類毒素。
毒性體克綜合重量毒素Ⅰ
(Toxic shock syndrome toxin1,TTST1) 系噬菌體Ⅰ群金黃色葡萄球菌產生。可引起發熱,增加對內毒素的敏感性。增強毛細血管通透性,引起必血管紊亂而導致休克。
其他
葡萄球菌尚可產生葡激酶(Staphylokinase),亦稱葡萄球菌溶纖維蛋白酶(Staphylococcal fibrinolysin),產生耐熱核酸酶(Heat-stable nuclease),透明質酸酶(Hyaluronidase),脂酶(Lipase)等。
毒性疾病
 表皮葡萄球菌
表皮葡萄球菌表皮葡萄球菌是葡萄球菌中的一種,對人體危害較小,詳見下表。
表皮葡萄球菌
表皮葡萄球菌微生物學診斷
不同病型採取不同檢材如膿汁、血液、可疑食物、嘔吐物及糞便等。
直接塗片鏡檢
取標本塗片,革蘭氏染色後鏡檢,根據細菌形態,排列和染色性可作出初步診斷。
分離培養與鑑定
將標本接種於血瓊脂平板,甘露醇和高鹽培養基中進行分離培養,孵育後挑選可凝菌落進行塗片、染色、鏡檢。致病性葡萄球菌的主要特點:凝固酶產生陽性,金黃色素,有溶血性,發酵甘露醇。
食物中毒病人的嘔吐物,糞便或剩餘食物在作細菌分離鑑定的同時,接種於肉湯培養基中,孵育後取濾液注射於6~8周齡的幼貓腹腔,注射後4小時內發生嘔吐、腹瀉、體溫升高或死亡提示有腸毒素存在的可能。這年來,採用免疫學方法檢測葡萄球菌腸毒素繁多,如反向間接血凝、ELISA、放射免疫等方法較快速敏感。
防治原則
加強衛生宣傳教育,講究個人衛生,皮膚創傷應及時處理,注意中西醫結合,合理用藥避免濫用抗生素。
病例討論
表皮葡萄球菌是廣泛存在於皮膚表面的條件致病菌,隨著抗生素的廣泛套用,醫療技術的進步,該菌已成為免疫缺陷者醫院內感染(包括傷口感染和插管感染)的常見致病菌,其引起敗血症,慢性前列腺炎的趨勢以日俱增。
 表皮葡萄球菌結構圖
表皮葡萄球菌結構圖表皮葡萄球菌的耐藥現象非常嚴重,文獻報導其對廣泛套用的青黴素、氨苄西林、苯唑西林、紅黴素的耐藥率高,本組的藥敏試驗結果也證實此點。表皮葡萄球菌對很多抗生素耐藥主要是與它產生β-內醯胺酶有關,院內、外分離的表皮葡萄球菌產β-內醯胺酶者超過80%,因此,臨床上治療表皮葡萄球菌所致疾病較為棘手。正確地選用抗生素尤為重要。本組藥敏試驗提示表皮葡萄球菌對下列藥物較為敏感:環丙沙星(80%)、萬古黴素(71%)、阿米卡星(69%)、利福平(48%)、頭孢唑啉(46%),其中環丙沙星更為突出。因此,當我們考慮有表皮葡菌球菌感染的可能性時,應首選環丙沙星及阿米卡星聯合治療,再根據藥敏結果和臨床治療反應作及時調整
呼吸內科疾病
| 研究範圍及進展呼吸內科是研究呼吸系統疾病的學科。它是既古老又年輕的學科,說它古老是因為,自從人類認識疾病以來,呼吸系統疾病就一直是危害人類健康的常見病和多發病,八十年代中期的統計資料表明,呼吸系統疾病仍然是導致死亡的主要疾病。在死亡的順序上排列第二。現在我們來認識一下這些可怕的疾病吧? |
盤點與我們一同生活的微生物
| 每個人都覺得自己是孤獨的,但全部知道有無數的細菌陪在我們的身邊,讓我們來好好認識一下它們吧! |

